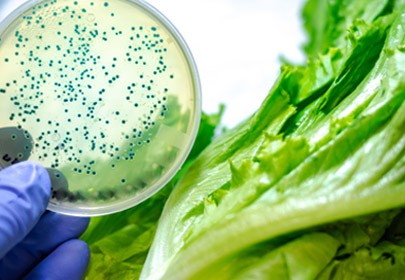
The impact of oregano (Origanum heracleoticum) essential oil and carvacrol on virulence gene transcription by Escherichia coli O157:H7

Le contrôleur de gestion est un véritable partenaire pour les départements Achats, Ventes, E-Commerce, Marketing et...
-
MenuRetour
-
Le Groupe INULA
-
-
-
À travers ses 3 marques, le Groupe Inula se spécialise dans les grandes thérapies naturelles : l’aromathérapie, la gemmothérapie et les remèdes aux plantes biologiques.
-
-
-
-
-
-
Le Groupe Inula
-
-
À travers ses 3 marques, le Groupe Inula se spécialise dans les grandes thérapies naturelles : l’aromathérapie, la gemmothérapie et les remèdes aux plantes biologiques.
-
-
-
-
-
-
commander
-
-
commander
-
-
Biofloral
-
-
Réserver une formation
-
-
-
>>> DEVENEZ CLIENT
pour participer à nos formations réservées aux professionnels -

-
-
-
Apprenez ce qu’est l’aromathérapie, la gemmothérapie et la thérapie par les elixirs floraux.
-
-
-
- Devenir client PRO
- Fiches d'analyse
-
Choisir un pays de livraison
-
- Mon compte
Rechercher dans blog
Catégories de blogs
Derniers articles

Basé(e) à Paris, vous faites partie du département Digital, sous la responsabilité du E-commerce Manager, et vous...

Basé(e) à Paris, vous faites partie du département Digital sous la responsabilité du Responsable E-commerce &...

Au départ du site de Ghislenghien, en tant que Laborantin/gestionnaire d’analyse pour les matières premières et...

Le chargé de l’assurance qualité (QA) doit s’assurer de la conformité de toutes les activités produits dans le...
Articles populaires

Aucun article trouvé











